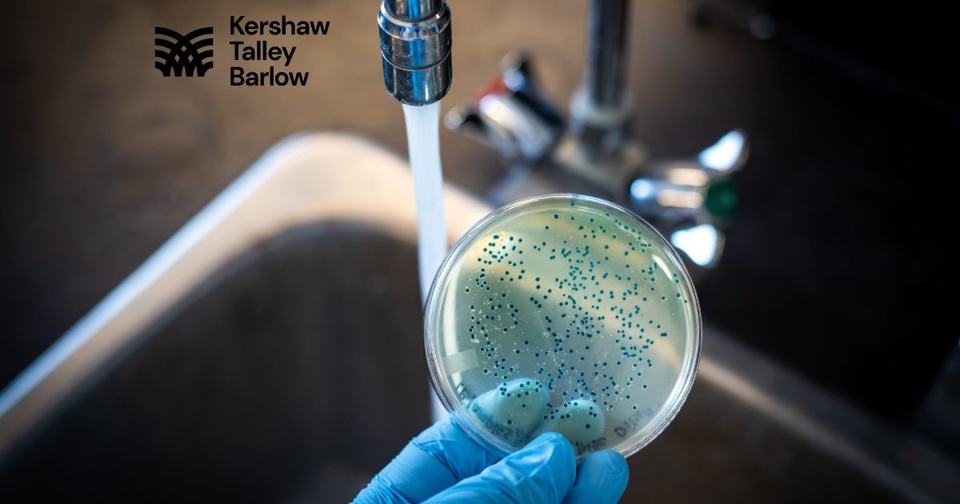

Most Recent Posts in Environmental Contamination
-
 Fifth Circuit Revives Constitutional Claims in Jackson, Mississippi Water Crisis Class Action
Fifth Circuit Revives Constitutional Claims in Jackson, Mississippi Water Crisis Class Action -
 Is Your Child’s School Prepared for the New Year? The Hidden Threat of Summer Lead Testing
Is Your Child’s School Prepared for the New Year? The Hidden Threat of Summer Lead Testing -
 California's Lead Problem in Schools: What It Means for Parents and Students
California's Lead Problem in Schools: What It Means for Parents and Students -
-copy-6[1].2401091257550.jpg) What to Know About the Groundwater Contamination West of Spokane
What to Know About the Groundwater Contamination West of Spokane -
[3].2401091116550.jpg) What to Know About the Ongoing Camp Lejeune Lawsuits
What to Know About the Ongoing Camp Lejeune Lawsuits -
 Where Are You Most Likely to Get Lead Poisoning?
Where Are You Most Likely to Get Lead Poisoning? -
A History of Water Contamination Cases In the US
A History of Water Contamination Cases In the US -
1,700 Child Care Centers in California Test Positive for Unsafe Lead Contamination
-
 Why Does Water Pollution Occur On Military Bases?
Why Does Water Pollution Occur On Military Bases? -
 Check Your Tap Water
Check Your Tap Water -
 Camp Lejeune Justice Act Has Passed, Benefitting Veterans
Camp Lejeune Justice Act Has Passed, Benefitting Veterans -
 What Businesses Need to Know About Proposition 65
What Businesses Need to Know About Proposition 65

